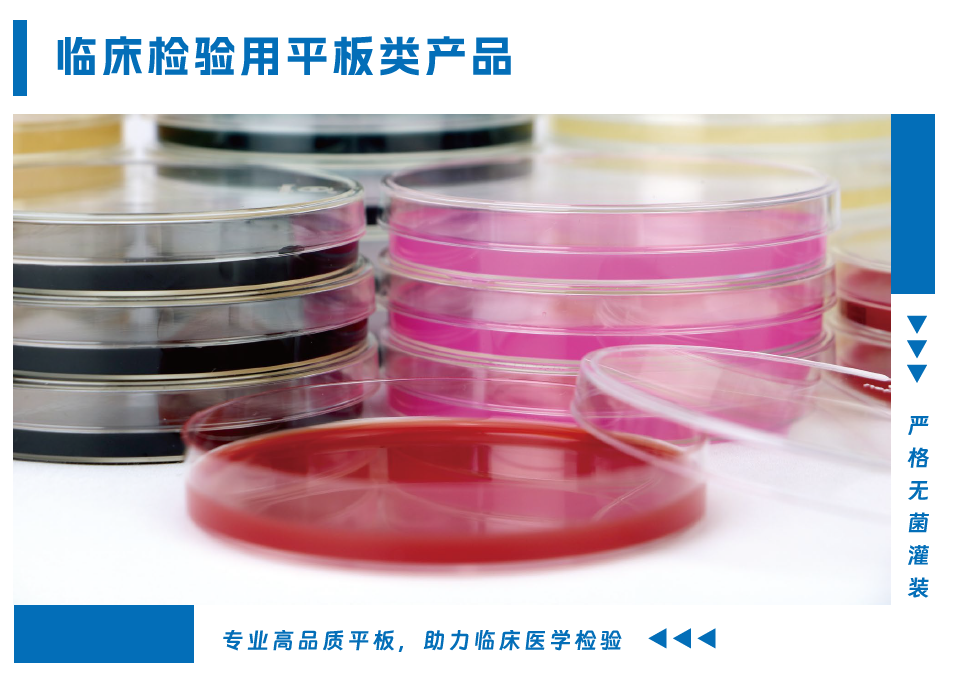

海博微信公众号
海博微信公众号
 海博天猫旗舰店
海博天猫旗舰店


 海博微信公众号
海博微信公众号
 海博天猫旗舰店
海博天猫旗舰店


一本在手,检测无忧
首版临床产品目录上线
一键解锁临床检验高效解决方案
青岛海博生物首版《临床检验系列产品目录》上线!
从检验平板到院感采样,从细胞培养到智能设备——9大系列、精准分类。助您快速匹配需求,提升工作效率!

核心亮点
1.精准检验,一步到位
临床检验平板系列,高灵敏度、低误差率,确保检测结果快速可靠。
2.食源监测,安全护航
致病菌检测平板,符合国标要求,助力食源性疫情早发现、早防控。

3.院感防控,专业采样
院内感染监测采样套装,无菌设计、操作简便,降低交叉感染风险。

4.细菌/病毒,保存无忧
运送保存管、病毒采样管(VTM)系列,多重防护设计,确保样本活性的同时,保证运输零泄漏、零污染。


5.菌种保存,细菌染色
菌种保存管涵盖瓷珠菌种保存管,液体菌种保存管,确保菌种活性,支持-80℃超低温保存,复苏成功率>95%
细菌染色,快速精准,涵盖革兰氏染色液,吉姆萨染色液、荚膜染色液等多种常用染色剂,镜检结果清晰易辨,更易判读。


扫描二维码
获取PDF版资料




